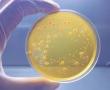

Petroleum Resins Market to Witness an Outstanding Growth by 2024 - 2031 | Arakawa Chemical Industries
The Petroleum Resins Market is estimated to be valued at USD 3.20 Bn in 2024 and is expected to reach USD 5.27 Bn by 2031 BURLINGAME, CALIFORNIA, UNITED STATES, June 19, 2024 /EINPresswire.com/ -- Market Overview: Petroleum resins are amorphous …